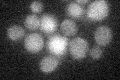
YNR065C
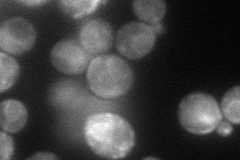
YNR065C

View description
Protein of unknown function; protein-protein interactions suggest a possible role in actin patch formation; YNR065C is not an essential gene
Localization:
Intensity:
Fold change:
Significance:
-
C’ GFP library in SD
below threshold16.53 -
N' NOP1pr-GFP in SD
ER81.2721 -
N' TEF2pr-mCherry in SD

ER,vacuole24.6358 -
N' NATIVEpr-GFP in SD

mitochondria20.4479 -
N' TEF2pr-VC and Cyto-VN in SD

#N/A0 -
C’ GFP library in SD+DTT

cytosol15.320.92No -
C’ GFP library in SD+H2O2

cytosol18.361.11No -
C’ GFP library in Starvation Media

cytosol15.520.93No -
C’ GFP library on the background of Pup2-DaMP

below threshold -
C’ GFP library on the background of CCT mutant

below threshold17.14061.03663No
